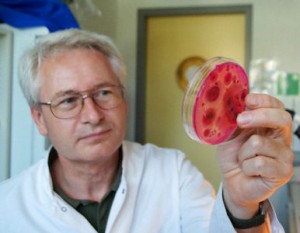

La llegada a la Tierra según los cálculos de los científicos, debe ser a mediados de diciembre de 2012. Fecha que coincide con el final del calendario maya.Algunos objetos de gran tamaño estan acercándose a la Tierra muy rápidamente – dice el astrofísico Craig Kasnov de proyecto SETI. Pero para que puedas comprobarlo por ti mismo, se recomienda ir al sitio SKY-MAP.ORG e introduzca las siguientes coordenadas para ver de los objetos :
19 25 12 -89 46 03 – el gran objeto primero
16 19 35 -88 43 10 – un objeto cilíndrico
02 26 39 -89 43 13 – el objeto como un círculo
Los participantes del proyecto han asegurado que los objetos son absolutamente reales, y la agencia espacial estadounidense NASA está tratando de ocultar información importante.
Ninguno de estos objetos se pueden ver desde el hemisferio norte.

El segundo conjunto de números en cada línea nos dice que el “objeto” u “objetos” vienen del Espacio muy profundo del hemisferio sur.
En cualquier caso, lo único que podemos hacer ahora – ¡agárrense! – Dice Kasnov. – Pronto objetos celestes serán visibles en el cielo con un buen telescopio.. ---------------------------------------------------------------------------------------------------------------------------------- ¿Ha descubierto el Instituto SETI tres objetos con dirección a nuestro mundo? ¿Naves extraterrestres que llegarán en el año 2012?
todo esto es una tontería -es un rumor, una falsedad y una fábula creada por sitios webs sin sentido crítico que la han publicado a su vez sin ningún tipo de verificación.Varios aspectos de esta historia son obviamente sospechosos:
Los objectos, actualmente descritos con un tamaño de algunos cientos de kilómetros y que se encuentran “mas allá de la órbita de Plutón”, fueron aparentemente descubiertos por SETI usando el arreglo de radio HAARP. Por principio de cuentas, el HAARP (por sus siglas en inglés Programa de Investigación Auroral Activo de Alta Frecuencia) es un instrumento ubicado en Alaska. La posición de los tres “objetos” tiene una declinación de -90 grados- es decir, están ubicados hacia el polo sur celeste. ¡Cualquier persona con un conocimiento mínimo de geometría elemental puede darse cuenta de que no se puede observar esa parte del cielo desde Alaska! Además, ninguno de los proyectos del Instituto SETI o de otros proyectos SETI hacen uso de este instrumento HAARP.
En la versión original de este artículo http://www.examiner.com/ufo-in-canada/3-very-large-objects-space-flying-to-earth, el supuesto astrofísico de SETI Craig Kasnov es citado afirmando que tres objetos estan en el límite. Nadie llamado Craig Kasnov ha trabajado nunca para el Instituto SETI. Existe un profesional de los medios y conservación llamado Craig Kasnoff, quien – junto con David Gedye – tuvieron la idea del protector de pantalla de SETI@home hace muchos años. Pero ha sido explícitamente resaltado que no tiene nada que ver con esta historia, de hecho el artículo mismo hace referencia a que es “Kasnov” y no “Kasnoff”. Así que esta historia se sustenta en un personaje ficticio.
Si el Instituto SETI hubiera de verdad descubierto tres objetos claramente artificiales dirigiéndose a la Tierra (o a cualquier otro lugar) las noticias estarían publicadas en el sitio web del Instituto (http://seti.org). También estarían en los principales medios de comunicación. Lo que no es así.
La supuesta llegada de estos objetos de otro mundo en el año 2012 es igual de poco creíble que la afirmación de que el calendario maya predice el fin del mundo en el mismo año, ¡A pesar de las historias en Internet!

..lo cierto es que el circulo sobre Iran se estrecha cada dia mas... pese a que asesores militares de los yankiss le comunicaron a la Casa Blanca que debia dar puerta a la guerra en Irak en menos de 6 meses...pero toda esta movida no es nueva..a CIA en Irak coordino el ingreso de milicias kurdas a Irán... para desestabilizar al gobierno del moro ahmadineyad... fueron conjuntas con la movilización de otros grupos kurdos desde el sudeste de turquia... pais aliado de los yankis desde los tiempos de la Guerra Fría...
..los americanos estan pensando la posibilidad de no ser el primer ariete contra Teheran... pero a la vez piensan en los escenarios que se desarrollarian en caso que sea Israel quien bombardee en primera instancia a Irán...en fin asi esta el patio..segun mi punto de vistaa..